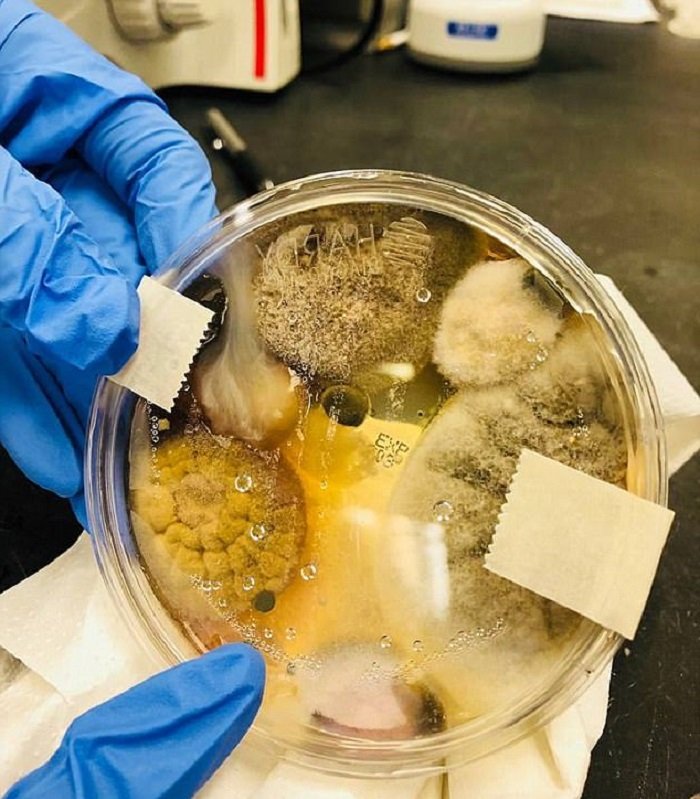
сушилка в общественном туалете

Всё большее количество общественных туалетов вместо ставших привычными бумажных полотенец предлагают традиционные или супербыстрые сушилки для рук, обещающие полный эффект всегда за 10 секунд. Впрочем, у этих чудо-устройств есть и существенные недостатки, которые связаны не только с сухостью кожи рук в дальнейшем.

Недавно жительница Калифорнии Николь Уорд, которая работает в лаборатории, решила проверить одну из сушилок на наличие в ней вредоносных бактерий. Какими окажутся результаты и действительно ли сушилки для рук имеют множество минусов или это просто навеянный миф, расскажет «Так Просто!».

Cушилка для рук электрическая
Николь Уорд проверила на наличие бактерий одну из современных сушилок для рук в туалете общего пользования и опубликовала результат на своей странице в соцсети. Как оказалось, их там уйма. Это не удивительно, ведь бактерии есть везде, и это нормально.

Американка показывает чашку Петри и то, что в ней выросло за несколько дней после того, как она подставила ее под сушилку одной из распространенных марок всего на 3 минуты. Женщина говорит: «Это несколько штаммов возможных патогенных грибов и бактерий, которые являются причиной многих заболеваний, которые оказываются на ваших руках, тогда как вы уверены, что руки чистые».
Плохо то, что патогенные грибы переносятся на руки каждый раз, когда мы их сушим. Но чаще, они начинают развиваться в результате того, что люди не досушивают руки полностью и на них остается влага. А еще некоторые исследователи говорят, что мощный поток горячего воздуха работает во благо распространения микробов.

Николь также подчеркнула, что никого не пугает, а лишь хочет продемонстрировать подписчикам, что болезнетворные микроорганизмы могут подстерегать буквально повсюду. В свою очередь изготовитель мощных сушилок для рук компания Dyson провела исследование при участии ученых из Университета королевы Марии в Лондоне, в котором доказывалось, что сушилки столь же эффективны в уничтожении бактерий, сколь и полотенца.

Одно можем сказать точно, что сушилки для рук сильно пересушивают кожу, и дабы избежать зуда и стянутости, нужно всегда наносить увлажняющих крем на руки или перейти на бумажные полотенца (салфетки), или используй антибактериальный гель. И, конечно же, маленьким деткам лучше такими сушилками не пользоваться, ведь их кожа очень нежная.

Расскажи нам в комментариях, замечал ли ты негативное воздействие на руки сушилок в общественных туалетах и считаешь ли ты, что лучше пользоваться бумажными полотенцами. А также поделись исследованиями американки со своими друзьями в соцсетях!
Предыдущая 